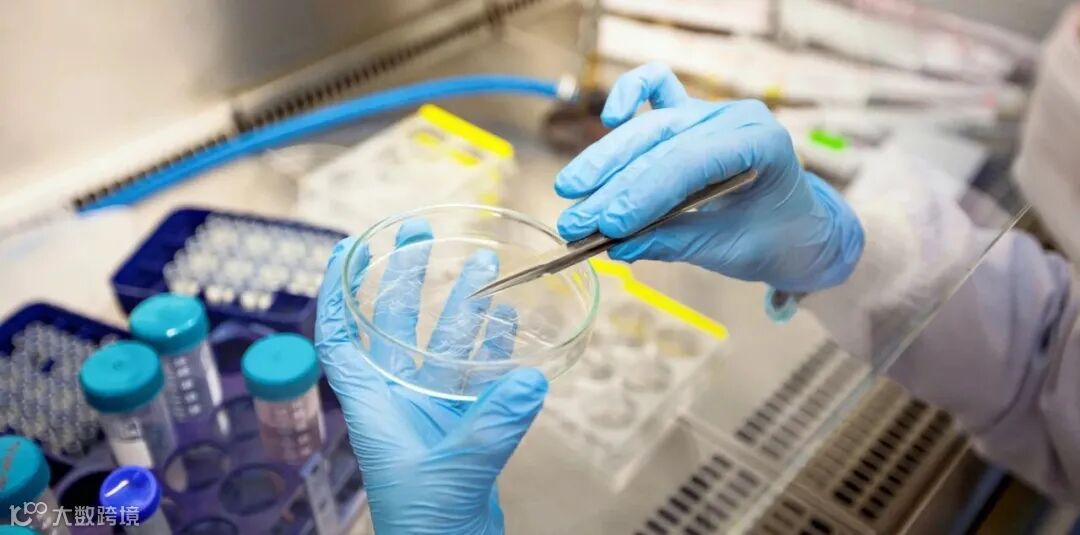

时光荏苒,岁月变迁。2023年5月16日,广州市比灵天然配料有限公司成立整整20周年。20年来,比灵配料紧扣行业热点,携手美国IFF 国际香料、马来西亚Custom Food 、新西兰TAURA 水果制品、美国Glanbia、丹麦Arla、日本nano等国际知名配料厂商,倾力打造风味、质构、营养、工艺等11个具有针对性的应用解决方案,将应用技术与前沿需求完美契合,助力食品厂商打造健康、美味、口感与营养兼具的竞争力产品。

今年正值比灵配料成立20周年,在20年的历练中,比灵配料始终坚持长期主义,坚守品质与创新,已经从单一的进口配料供应商成长为食品综合应用技术解决方案服务商,在泰斯特食品技术 的加持下,用专业的技术,完善的服务机制为客户提供从概念设计、研发配方、制作样品、样品测试及工艺改良的一套完整的技术应用解决方案。
未来,比灵配料将进一步满足厂商差异化、个性化、一站式的新需求,满足行业变革带来的产品、技术、工艺供采新机遇,助力食品工业行业的转型升级与高质量发展,面向全国,放眼世界,不断在品牌年轻化、时尚化、高端化上做文章,在产品创新、管理创新、市场创新上下功夫。
▼往期精彩回顾▼
往期推荐


